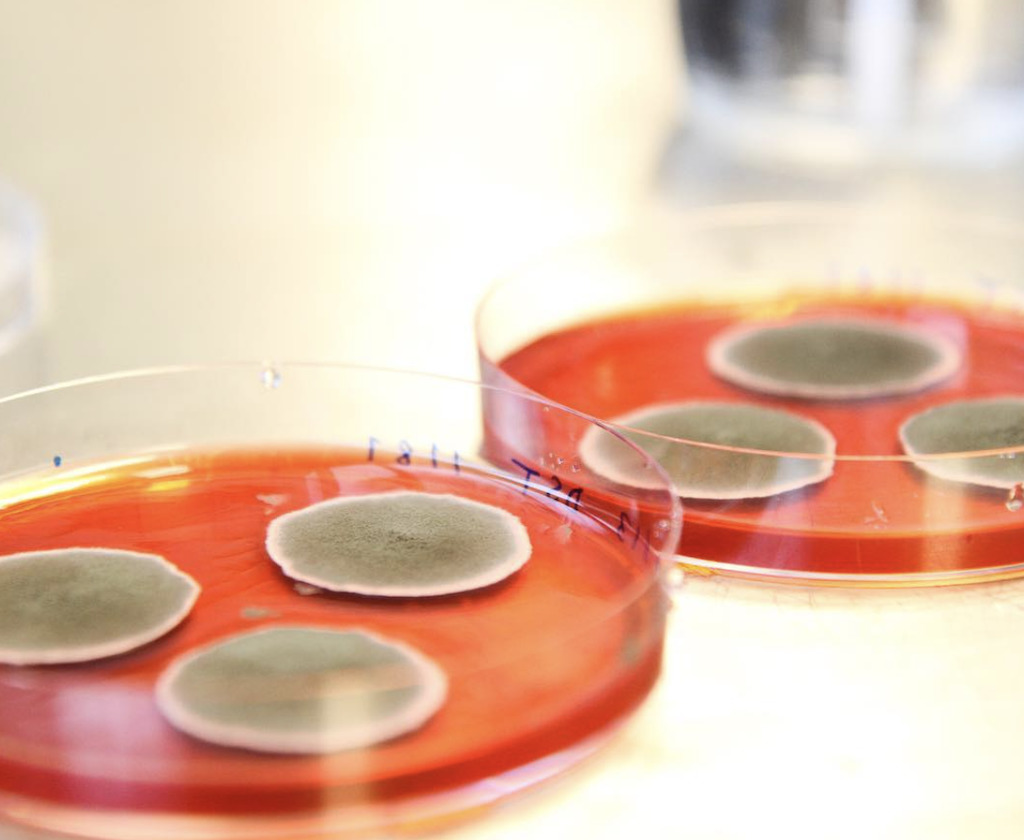

Chromologics: Startup Disrupts US$2B Food Colourant Market With Animal-Free Fermentation-Based Solution
A spin-out venture from the Technical University of Denmark is set on disrupting food colourants, a US$2 billion global industry still reliant on animal-derived ingredients. Using fermentation technology, Chromologics is developing a platform of high-performing food colourants that are animal-free, sustainable and ethical.
Chromologics was born in 2017 and came out of research from the Technical University of Denmark. The startup has a biotechnological colourant platform, offering next-generation food-grade colourants that are functional and high-performing, but are not derived from any animal ingredients – unlike current conventional food colourants like carmine, a red pigment made from crushed beetles and cochineal insects.
While there are some natural plant-based food colourant alternatives on the market right now, often made from high-value raw value materials like fruit and vegetables, this Danish startup believes that their alternative has a bigger disruption potential given its scalability and cost-effectiveness. Chromologics uses fermentation technology to produce their natural colourants, made from non-GMO fungal strains, in a process that is not only sustainable, cruelty-free but can be produced cheaply and on a large-scale to meet the needs of the enormous US$2 billion dollar food colourant industry.
Their flagship red dye, called ChromoRed, has an optimal pH and temperature stability, making it applicable in a wide range of food products. The pigment is compatible with many dietary needs, including kosher, halal, and vegan diets.

[Investors] recognise the extraordinary economic opportunity in introducing lab-grown food colorants to the market at a time where alternative meats and food safety is a high consumer demand.
Gerit Tolborg, CEO, Chromologics
It’s already won support from a number of investors in a €1.9 million (approx. US$2.3 million) seed round last year, which saw participation from the venture capital arm of Danish asset manager and life sciences investor Novo Group, the Danish growth fund Vækstfonden, and Nordic FoodTech VC.
At the time, Chromologics says the proceeds will be used to push forward the regulatory approval of its product, which comes at a time when consumer awareness over food safety, sustainability and interest in veganism is at an all-time high. The startup also revealed that it is in “ongoing discussions” with various commercial partners for a collaborative roll-out of its fermentation-derived colourant platform.
Commenting on their recent seed round, Chromologics CEO Gerit Tolborg said: “Their support provides validation for our strategy to develop better and more sustainable food colorants. They recognise the extraordinary economic opportunity in introducing lab-grown food colorants to the market at a time where alternative meats and food safety is a high consumer demand.”
“This investment will allow us to accelerate the development of our flagship product ChromoRed and maximise the potential of our platform as we develop food colorants that meet the needs of industry and consumers,” Tolborg added.
Chromologics isn’t alone when it comes to tapping fermentation technology to create food colourant alternatives, although the group of startups doing so is admittedly small. In Israel, Phytolon is also leveraging fermentation to produce natural food colourants in baker’s yeast, and their technology was born out of research from the Weizmann Institute of Science.
Currently, the firm is conducting proof-of-concept experiments of their product’s performance at the production lines of major food industry players, and says its latest US$4.1 million funding will help them forge more partnerships with the food companies and manufacturers ahead of its go-to-market plans.
Professor Asaph Aharoni of the Weizmann Institute of Science, who was a key inventor of the proprietary fermentation process that Phytolon uses, believes that sustainable and ethical alternatives for food colourants is critical to the broader goal of fixing our global food system.
“[It’s] a step forward towards reducing the segment of synthetic chemistry and increasing sustainability of natural resources for the food industry,” said Aharoni.
All images courtesy of Chromologics.



